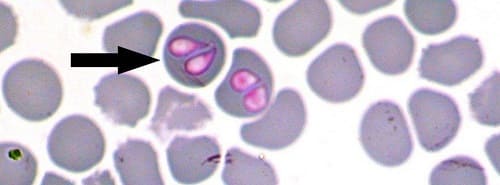

Пироплазмоз (бабезиоз) – это тяжелое заболевание, которое развивается после укуса иксодового клеща. Если насекомое заражено паразитом бабезия, простейшее инфицируется в кровоток собаки. Там оно разрушает красные кровяные тела, чтобы добыть себе гемоглобин для питания. В итоге ткани животного ощущают кислородное голодание. Кроме того, оболочки эритроцитов засоряют сосуды, сбиваются в тромбы, застревают в протоках и каналах.
Осложнения болезни
Бабезиоз опасен осложнениями, которые наносят организму питомца большой урон. Поэтому реабилитация собаки после пироплазмоза включает в себя прием лекарственных препаратов, уменьшение физических нагрузок, соблюдение диеты.
Массовая гибель эритроцитов приводит к развитию анемии. Она проявляется побледнением десен, быстрой утомляемостью, отказом от прогулок. Оценив результаты анализа крови, ветеринар назначает лечение. Оно состоит из принятия лекарственных препаратов с железом и калием, соблюдения диеты.
В тяжелых случаях требуется переливание крови, трансплантация костного мозга.
Продукты распада эритроцитов соединяются в тромбы и закупоривают почечные канальцы. Симптомы болезни – частые позывы в туалет, недержание мочи, жажда от обезвоживания, общая вялость питомца. Определить патологию поможет анализ мочи на кислотность, белок и сахар, УЗИ органов выделительной системы. Во время лечения ветеринару нужно восстанавливать функцию мочеиспускания, кислотно-щелочной и электролитный баланс.
Продукты жизнедеятельности паразита отравляют печень, вызывая токсический гепатит. Он проявляется потемнением мочи, осветлением кала, пожелтением слизистых оболочек. Собака страдает от тошноты, диареи, рвотных позывов. Для подтверждения диагноза проводится биохимический анализ крови. Лечение заключается в приеме гепатопротекторов, составлении рациона из диетических продуктов.
Кислородное голодание тканей заставляет органы дыхательной и сердечно-сосудистой системы работать в ускоренном режиме. Пес шумно дышит, отказывается от пищи и прогулок, падает в обмороки. В этом случае собаку нужно везти на кардиологическое обследование. При тяжелом состоянии питомца оставляют для лечения в клинике. Легкую аритмию устраняют в домашних условиях путем уменьшения физических нагрузок и коррекцией питания.
Медикаментозное лечение
Восстановление здоровья собаки после пироплазмоза осуществляется комплексным способом. Тяжелые стадии анемии, интоксикации, обезвоживания, аритмии устраняются с помощью капельниц. Собаку оставляют в клинике, чтобы она находилась под круглосуточным наблюдением специалистов.
Реабилитационный период продолжается приемом лекарственных препаратов для восстановления функций ослабленных органов.
Ветеринар может прописать такие лекарства.
Препарат Преднизолон подавляет судороги, устраняет аллергические реакции. Он блокирует перемещение белых кровяных телец в зону воспаления, чем улучшает общее состояние организма. Для первого приема дозировка рассчитывается по весу собаки. Далее в процессе выздоровления доза уменьшается. Противопоказаниями к приему лекарства выступает почечная недостаточность, язвы и проблемы с ЖКТ.
Препарат помогает крови восстанавливаться, так как фолиевая кислота участвует в производстве красных кровяных телец. Дозировка таблеток рассчитывается после расшифровки клинических анализов. В норме у собаки должно быть 8-15 мкг вещества на 1 кг веса. Противопоказанием является повышенная чувствительность к элементу.
Помните, длительный бесконтрольный прием лекарства приводит к снижению концентрации витамина цианокобаламина.
Препарат помогает печени справиться с токсинами, восстанавливает клетки органа, стабилизирует уровень желчи. Он принимается длительным курсом: от двух недель до нескольких месяцев. Лекарство дают перед каждым приемом пищи. Собаки крупных и средних пород заглатывают по одной капсуле. Для мелких декоративных песиков разрешается вскрыть оболочку и разделить желеобразное содержимое на 2-3 части.
Правила питания
Диета собаки после лечения пироплазмоза составляется ветеринаром. Он учитывает, какие органы получили наибольшее повреждение, и каково общее состояние здоровья. Кормить питомца необходимо небольшими порциями 4-5 раз в день. Еда должна быть легкоусвояемой, теплой, перетертой до консистенции пюре, а вода – чистой и свежей.
При анемии в меню собаки включают пропаренные субпродукты. При ослаблении функции печени следует готовить мясо нежирных сортов, каши из молотой крупы, а овощи подвергать термической обработке. При почечной недостаточности в основу рациона вводятся супы и каши, приготовленные на втором бульоне. При этом запрещено использовать продукты, вызывающие брожение, запор, диарею.
Если собака до и во время болезни питалась готовым кормом, не стоит переводить ее на натуральные продукты в период реабилитации. Многие фирмы-производители выпускают качественную продукцию специально для ослабленных питомцев. Паштеты, консервы и подливки необходимо подогреть до 40°. Сухие гранулы следует размягчить теплой водой.
Советы ветеринаров
В период реабилитации после пироплазмоза необходимо ограничить физическую нагрузку собаки. Однако надолго запирать ее в квартире не стоит. Если питомец хорошо себя чувствует, выводите его ненадолго на улицу. Там он может найти себе полезную траву, подышать свежим воздухом, нагулять аппетит.
Когда пес выздоровеет и окрепнет, обезопасьте его от клещей с помощью ошейника, спрея, капель на холку. Для многих пород собак изготавливают комбинезоны с защитой от паразитов. После каждой прогулки осматривайте кожу питомца, расчесывайте его шерсть, разбирайте колтуны.
Допустим, что профилактика укусов инфицированных клещей не помогла, выполненные своевременно прививки от пироплазмоза тоже не помогли и ваша собака переболела этим страшным заболеванием. Проведённое лечение дало эффективные результаты и острая стадия заболевания позади.
Однако, праздновать победу рано. Увидеть вовремя симптоматику заболевания и провести соответствующее лечение еще не все. Пироплазмоз может иметь страшные последствия. Для полного восстановления организму животного нужно время и помощь со стороны человека.
Какие возможны последствия
Перенесённый пироплазмоз часто оставляет за собой тяжелые последствия. Они могут быть ярко выраженными или носить скрытый характер. Их величина напрямую зависит от индивидуальных особенностей собаки и от того насколько правильно и своевременно было начато лечение.
Основными последствиями могут быть:
- поражение деятельности центральной нервной системы;
- патологии сердца;
- частичная анемия, как результат дефицита эритроцитов;
- нарушения функций почек и печени.
Какие бывают осложнения
Коварный пироплазмоз не проходит бесследно и любые осложнения, связанные с ним, наносят непоправимый вред здоровью собаки.
| Наименование осложнения | Краткое описание |
|---|---|
| Почечная недостаточность. | Пораженные бабезией эритроциты способны закупорить почечные каналы. |
| Отравление клеток нервной системны (полное либо частичное). | В период протекания заболевания и в период лечения истощается нервная система, её клетки отмирают и не восстанавливаются |
| Нарушение зрения, либо полная слепота | Токсические вещества оказывают отрицательное воздействие на органы зрения в целом |
| Гепатопатия | Поражения печени, возникающая в процессе воздействия на организм химических соединений больших в количествах. |
| Анемия (нарушение работы сердечной мышцы) | Кислородное голодание вызывает нагрузку на сердечную мышцу, вследствие чего появляется анемия. Анемия определяется анализом, показывающим низкое содержание в крови собаки дееспособных красных телец. |
| Синдром ДВС | Проявляется, как нарушение гемостаза, образованием в крови сгустков фибрина, а также тромбоцитов и эритроцитов (в последствии оседающих в капиллярах и вызывающих в них дистрофические изменения). |
| Некроз мускулатуры | Вызван нарушением микроцеркулярного кровеносного русла. |
| Церебральный синдром | Наиболее опасен, его причина – это эндотелиальная дисфункция, а также нарушение деятельности и микроциркуляции сосудов головного мозга |
| Респираторный синдром | Диагностируется, как дыхательная недостаточность и отёчность лёгких |
Осложнения пироплазмоза могут быть вызваны не только самим заболеванием, но и его лечением.
 Реабилитация после излечения
Реабилитация после излечения
Период реабилитации собаки после пироплазмоза длительный и крайне важный для жизнедеятельности её организма. Несмотря на то, что животное выглядит здоровым и не проявляет внешних признаков болезни, ему требуется уделять максимум внимания:
Основная цель периода реабилитации- максимально быстрое избавление от последствий присутствия бабезий-паразитов в организме собаки.
Препараты назначает только лечащий врач. Не занимайтесь самолечением – это может привести к непоправимым последствиям.
Печень собаки, пораженная пироплазмозом, требует поддержки и лечения. Лишь в этом случае она способна к полной регенерации (восстановлению). Вашему четвероногому другу могут быть прописаны:
- Антибиотики.
- Анальгезирующие желчегонные, мочегонные средства, поливитамины.
- Препарат для лечения печени: Карсил, Эссенциале Форте и другие.
- Средства желчегонного и мочегонного направления.
- Поливитамины.
- Гомеопатическое лечение.
- Специальная диета.
В период восстановления печени собака должна вести спокойный образ жизни и не переутомляться, принимать лекарственные препараты. Питание в этот период должно быть максимально качественным и сбалансированным. Существуют специальные сухие корма из категории интенсивной терапии.
Рацион питания и диету после пироплазмоза собаке назначает лечащий врач. Правильно подобранное и сбалансированное питание может помочь в окончательной победе над страшным недугом.
Основным рационом питания, для собаки, в это время является тот же самое, что и во время болезни. Кроме того, необходимо запомнить основные правила реабилитационного кормления и ухода:
- Порции питания сократить в половину, а частоту приёма пищи увеличить.
- Кормить можно натуральным или сухим кормом для больных животных (по назначению ветврача).
- Пища должна быть свежей, качественной, содержать антиоксиданты и иметь высокую энергическую ценность.
- Предпочтительна пища жидкая (мочегонная), которая будет стимулировать выведение токсинов.
- Пища должна быть тёплой и разнообразной.
- Исключается кормление сырыми продуктами.
- Сухой корм рекомендовано размачивать.
- Требуется обильное питьё.
| Разрешённые продуты | Запрещённые продукты |
|---|---|
| Крупяные каши: рис, гречка (пшено) | Крупы кроме разрешенных, |
| Не жирное мясо (курица без кожи, индейка, говядина) | Сырое мясо, субпродукты, кости |
| Тушеные овощи (морковь. кабачок, тыква, брокколи, цветная капуста) | Белокочанная капуста, картофель, яблоки, свекла. |
| Нежирные сорта рыбы | Речная рыба, жирная рыба |
| Кефир, творог | Молоко |
| Яйца варёные | Сладкое, мучное, солёное, острое. |
| Мясное пюре, ЗОО консервы, фарш отварной | Полуфабрикаты и колбасные изделия |
| Вторничный (обезжиренный) бульон | Еда с человеческого стола |
Длительность восстановительного периода

- насколько серьёзно пострадали жизненно важные органы животного;
- возраст животного и общее состояние здоровья (старые собаки и щенки находятся в 1-ой группе риска);
- породные особенности и генетические предрасположенности;
- своевременность и правильность лечения.
По окончании реабилитационного периода следует провести общий осмотр собаки у врача и сдать необходимые анализы. Это нужно для того, чтобы выяснить в каком состоянии находится ваш питомец и нет ли угрозы обострения болезни (в любом её проявлении).
Другие интересные статьи на эту тему
Знание первичных симптомов опасного заболевания поможет быстрее отреагировать на ситуацию и спасти четвероногого друга от летального исхода. Подробнее читайте здесь
Иксодовые клещи – это настоящий бич современности. Особую опасность они представляют для собак. Во имя защиты своих любимых питомцев владельцы ищут спасительную вакцину. Подробнее читайте здесь
Заключение
Каждый случай заражения собаки пироплазмозом и каждый пёс индивидуальны. Не существует единого подхода к лечению и метода дальнейшей реабилитации. Ни одна собака не способна самостоятельно излечиться от последствий пироплазмоза. Её будущее зависит от того, насколько ответственно хозяин подойдёт к этому вопросу.
Пироплазмоз – это природно-очаговое кровепаразитарное заболевание, вызываемое простейшими микроорганизмами – пироплазмами. Кроме собак встречается у лисиц, енотовидных собак, других пушных зверей, а также у мелкого и крупного рогатого скота, лошадей, свиней. Возбудители пироплазмоза специфичны для каждого вида животных.
Заболевание, его возбудители и переносчики
Возбудители пироплазмоза собак – Piroplasma canis – одноклеточные, беспигментные паразиты крови из рода Piroplasma Patton (пироплазма паттон), в связи с чем заболевание чаще носит название пироплазмоза, и семейства Babesiidae Poche (бабезиида пош), поэтому иногда заболевание встречается под названием бабезиоза.
Паразитируют в эритроцитах крови животных. В одном эритроците могут встречаться 1–2 особи, нередко больше – 4–16 и даже 32, возбудитель обычно заполняет весь эритроцит. При сильном поражении пироплазмы находятся также и в плазме крови.
Заболевание имеет широкое распространение во многих странах мира. Переносчиками пироплазмоза собак являются некоторые виды клещей, находящиеся в половозрелой (взрослой) стадии.
Особенно большой экономический ущерб они наносят в южных регионах, где существуют благоприятные условия для жизнедеятельности переносчиков заболеваний.
Пироплазмоз собак регистрируют весной и осенью, обычно через 2–3 недели после начала охотничьего сезона.
Развитие пироплазм у клеща и попадание их в организм собаки
После попадания пироплазм в организм клеща-переносчика вместе с эритроцитами крови они размножаются в его кишечнике, где проходят ряд стадий развития.
Затем они перемещаются в другие органы клеща (гемолимфу, яйцевые клетки), где также претерпевают множественные деления. После этого пироплазмы мигрируют в слюнные железы клеща, откуда попадают в организм животного-хозяина (например, собаки).
Клещи нападают на собак в теплый период года (обычно весной, с появлением первой растительности, и осенью). Передача возбудителя происходит при укусе клеща, что называется трансовариальным путем передачи.
Попавшие в кровяное русло паразиты внедряются в эритроциты и начинают достаточно быстро размножаться. При этом поражается огромное число эритроцитов.
Патологические процессы, происходящие в организме собаки после попадания пироплазм в кровеносную систему
И сами паразиты, и продукты их жизнедеятельности оказывают сильное токсическое воздействие на организм собаки, в первую очередь поражая центральную нервную систему.
Естественно, это приводит к нарушению работы многих других органов и систем; нарушается обмен веществ, образование клеток крови, работа иммунной системы. В ответ на все эти нарушения (т.е. компенсаторно) усиливается работа сердечно-сосудистой и дыхательной систем, которые в процессе развития заболевания начинают постепенно ослабевать.
Нарушение функции иммунной системы приводит к ослаблению защитных клеточных реакций на внедрение паразитов, а также подстегивает размножение пироплазм и дальнейшую гибель красных кровяных телец (эритроцитов).
Вследствие этого снижается газообмен, наступает кислородное голодание, и как следствие этого развиваются одышка и застойные явления.
Прогрессирующий распад эритроцитов приводит к понижению возможности обезвреживания токсичных продуктов жизнедеятельности пироплазм, они все больше и больше накапливаются в тканях организма, вызывая воспалительные процессы во многих внутренних органах.
Поражается печень с последующим нарушением процесса пищеварения, нарушается функция почек, что приводит к нарушению выделения токсических веществ из организма. Дисфункция сердца и специфические изменения в сердечной мышце, происходящие под воздействием токсических продуктов жизнедеятельности паразитов, способствуют ослаблению работы миокарда и нарушению кровообращения.
Часть гемоглобина перерабатывается в желчные пигменты, поэтому видимые слизистые оболочки (глаз, ротовой полости), кожа, подкожная клетчатка приобретают желтоватый оттенок. Процесс восстановления всех жизненных функций длительный и требует грамотной ветеринарной помощи.
Признаки заболевания
Инкубационный период заболевания, т.е. время, которое проходит от момента попадания пироплазм в кровь собаки до появления первых признаков заболевания, составляет 6–10 суток, иногда 20–30 суток. Заболевание может протекать со сверхострым, острым и хроническим течением. Щенки и старые собаки болеют особенно тяжело.
При сверхостром, или молниеносном, течении болезни наблюдается внезапная гибель собаки без проявления видимых признаков заболевания.
Острое течение характеризуется снижением или отсутствием аппетита, апатией, учащением и затруднением дыхания. Температура тела собаки повышается до 41–42оС (при норме 38,8–39оС) и остается на таком уровне 2–3 суток. Также учащается пульс, он становится нитевидным, затем аритмичным и плохо прощупывается.
Видимые слизистые оболочки бледнеют, приобретают синеватый оттенок, а на более поздней стадии поражения становятся желтушными (вследствие переработки гемоглобина в желчные пигменты). На 2–3 сутки моча становится красновато-коричневого цвета вследствие распада эритроцитов и выхода из них гемоглобина, который и окрашивает мочу.
При отсутствии лечения или при запоздалом лечении собака с каждым днем слабеет, задние конечности ослабевают, может развиться их паралич. Возникает нарушение функции кишечника.
Хроническое течение чаще встречается у ранее переболевших пироплазмозом собак, у беспородных, подобранных с улицы, или у собак с повышенной устойчивостью организма к заболеванию.
Периодически у собак отмечается то улучшение общего состояния, то вновь появляются признаки угнетения. Часто наблюдается изменение цвета и консистенции фекалий – они приобретают желтоватое окрашивание, появляется диарея (понос).
Без оказания ветеринарной помощи собаки при таком течении заболевания выздоравливают медленно – от 3–8 недель до 2–3 месяцев, поэтому все-таки лучше обратиться к специалисту.
Поставить правильный диагноз при такой смазанной картине заболевания бывает затруднительно, поскольку не все ветеринарные врачи при таких клинических признаках берут мазок периферической крови на предмет наличия паразитов в крови.
Лечение
При обнаружении в крови пироплазм требуется введение специфического препарата: беренила (азидина), пироплазмина, имидокарба или фенамидина. Любой из этих препаратов может вводить только ветеринарный врач.
Это связано с тем, что помимо специфического лечения (т.е. введения, например, беренила), собаке, как правило, требуется неспецифическое лечение, которое заключается во введении препаратов, понижающих температуру, поддерживающих функцию жизненно важных органов (сердца, почек, печени), снимающих интоксикацию и т.п.
Беренил сам по себе достаточно токсичен для организма, который при пироплазмозе и так функционирует на пределе. После введения препарата в условиях ветеринарной клиники собаке ставят капельницу с физиологическими растворами солей для возмещения потерь жидкости, восстановления кислотно-щелочного равновесия в клетках и снятия интоксикации.
Также вводятся препараты для поддержания функции сердечно-сосудистой, дыхательной и выделительной систем. В тяжелых случаях капельницу требуется ставить в течение 5–7 дней и, кроме того, бывает необходимо переливание крови.
При легком и хроническом течении достаточно однократного введения препарата, однократного или двукратного капельного введения физиологических растворов солей, витаминов группы В, препаратов железа и симптоматической терапии.
В домашних условиях владельцам необходимо самостоятельно проводить термометрию (т.е. два раза в день измерять температуру тела животного). У собак температуру измеряют с помощью обычного термометра: его смазывают вазелином или детским кремом и вводят в прямую кишку примерно наполовину. Держать в заднем проходе термометр следует не менее 3–4 минут.
Профилактика
К профилактическим мероприятиям относятся противопаразитарная обработка собак специальными спреями и использование ошейников от экзопаразитов (клещей, блох, власоедов). Владельцам охотничьих собак, чьи питомцы используются на охоте, рекомендуется одновременное применение противопаразитарных ошейников и обработка спреями.
При этом желательно, чтобы ошейник и спрей были одной фирмы-производителя. Спрей следует распылять вначале против шерсти собаки, затем по шерсти, особенно тщательно обрабатывая область паха, шеи и живота. Голову и уши необходимо обрабатывать аккуратно, чтобы спрей не попал в глаза или в пасть собаки.
Читайте материал «Мой друг Юшка»
После возвращения с охоты собаку следует сразу же внимательно осмотреть и уничтожить снятых с нее клещей. Особенно тщательно необходимо осматривать уши, шею, подгрудок, область паха.
При покупке противопаразитарных средств обращайте внимание на страну-производитель, покупайте препараты только известных фирм в крупных, хорошо зарекомендовавших себя зоомагазинах.
Перед использованием любого средства внимательно читайте приложенный к нему листок-вкладыш. Чтобы было проще сделать выбор, предварительно посоветуйтесь с ветеринарным врачом.
За рубежом разработали инактивированную вакцину против пироплазм, которая предотвращает случаи с летальным исходом, но не предотвращает заражение. Такая вакцина начинает появляться и у нас, но она пока не имеет соответствующей лицензии, поэтому не может быть использована в ветеринарной практике.
Пироплазмоз – сезонная трансмиссивная болезнь, которая распространяется иксодовыми клещами рода Dermacentor. На ранней стадии она купируется за 2 – 3 дня с помощью одного укола. В запущенных случаях развиваются тяжёлые осложнения, вплоть до гибели животного. В статье разберём, как развивается пироплазмоз у собаки, лечение, препараты, средства профилактики.
Как развивается пироплазмоз у собаки
Сейчас в ветеринарии чаще пользуются вторым названием болезни – бабезиоз. Собаки заражаются с марта до октября, когда температура воздуха поднимается выше плюс 5 градусов, и просыпаются иксоидные клещи. Вспышки регистрируют с апреля по июнь и августе-сентябре. Раньше собаки заболевали после прогулок в лесу, теперь пироплазмоз диагностируют и у городских собак.
Возбудители болезни – одноклеточные паразиты Piroplasma canis рода Babesia. Они передаются вместе со слюной клеща, куда попадают после укуса больного животного. Заражение здоровой собаки начинается через 48 часов после прикрепления паразита. Сначала вредитель выделяет цементирующий и обезболивающий секрет. Слюнные железы на этой стадии не работают. Потом клещ напитывается кровью. После полного насыщения часть впрыскивается обратно вместе с заражённой слюной.

Оставшиеся кровяные клетки не справляются с основной задачей – насыщать клетки кислородом. От гипоксии страдает головной мозг, сердечная мышца, печень, почки:
- Сердце и лёгкие работают с удвоенной силой, чтобы восстановить нормальный уровень кислорода в тканях.
- Ослабленные почки не справляются с выведением разрушенных эритроцитов.
- Печень не успевает перерабатывать ядовитые продукты распада гемоглобина, который в огромном количестве выходит из красных кровяных клеток.
- В организме скапливаются вредные продукты, наступает интоксикация.
- От гипоксии и действия токсинов разрушаются клетки головного мозга.
Внутренние изменения тяжелее переносят щенки, молодые собаки до года и пожилые животные после 9 лет.
Симптомы острого и хронического пироплазмоза
Инкубационный период пироплазмоза продолжается 7 – 10 суток. Это средний срок. Первые симптомы могут появиться и через 3 дня, и спустя 3 недели. В единичных случаях болезнь развивается за несколько часов.
Первые признаки острого пироплазмоза – изменение поведения животного:
- собака много спит;
- неохотно идёт на прогулки;
- постоянно пьёт;
- плохо ест или вообще отказывается от корма;
- резко подскакивает температура до 40 – 41 градусов.
Потом симптомы развиваются по нарастающей:
- Животное тяжело, учащённо дышит.
- Передвигается нетвёрдой походкой или вообще не встаёт на задание лапы.
- Меняется цвет мочи: от тёмно-жёлтого до кроваво-коричневого.
- Слизистые оболочки иссушаются, бледнеют, потом желтеют.
- Появляются признаки пищевого расстройства: понос со слизью и кровью, жёлтая рвота.
- Желтеют белки глаз, зубная эмаль.
- Учащается сердцебиение.
Пироплазмоз протекает в лёгкой и тяжёлой форме. В первом случае симптоматика ограничивается повышением температуры на градус, вялостью и ухудшением аппетита. В тяжёлых случаях проявляется большинство перечисленных признаков.
Хронический пироплазмоз развивается у собак с высокой устойчивостью к возбудителю, недавно переболевших животных. Симптомы смазываются, их легко спутать с другими болезнями:
- Температура поднимается в начале болезни на 1 – 2 дня, потом нормализуется.
- Самочувствие и поведение собаки неустойчивое. Вялость и апатия сменяются периодами улучшения.
- Поносы чередуются с запорами, кал иногда жёлтый.
- Появляются признаки анемии: бледнеют слизистые, слабеют мышцы.
- Периодически пропадает аппетит, животное истощается.
Острым пироплазмозом болеют домашние породистые собаки. Хроническая форма чаще развивается у крепких бродячих животных, домашних беспородных псов, метисов.
Диагностика пироплазмоза
Предварительный диагноз врач ставит по внешним признакам, учитывает сезон, места прогулки животного. Симптомы пироплазмоза напоминают другие болезни с похожими признаками: лептоспироз, патологии почек и печени, чуму плотоядных, отравления. Именно поэтому собаку нельзя оставлять дома. Без точного диагноза хозяин рискует лечить собаку не от той болезни, потерять время и ещё больше навредить животному.
Для уточнения диагноза в клинике проводят лабораторные исследования:
- Микроскопический экспресс анализ. В крови обнаруживаются разрушенные эритроциты, внедрённые в них пироплазмы. Иногда они не попадают в поле зрения, и исследование показывает ложно отрицательный результат.
- Микроскопический анализ окрашенного мазка. Этот метод диагностики точнее предыдущего. У животного берут периферическую кровь, чаще из уха. Затем смешивают с раствором, который расцвечивает клетки и их элементы в разные оттенки. Пироплазмы окрашиваются в голубой цвет, их ядра – красно-фиолетовый.
Пироплазмоз у собаки – лечение, препараты
Терапия включает 3 направления:
- уничтожение пироплазм антипротозойными препаратами;
- снятие интоксикации;
- поддерживающая терапия.
Конкретную схему назначает ветеринарный врач в зависимости от тяжести болезни.
Для уничтожения пироплазм применяют всего 2 вещества: диминазен или имидокарб. На их основе выпускают массу лекарственных препаратов:
С диминазеном:
|
С имидокарбом:
|

Если через сутки после укола в крови обнаруживают пироплазмы, то назначают повторную инъекцию. Препараты содержат дополнительный компонент феназон, он снимает жар, боль, подавляет вредные бактерии.
Лекарства с диминазеном уничтожают пироплазм в первые часы после укола, но они токсичны для печени и почек. У животных часто развиваются побочные симптомы. Развивается рвота, диарея. Усиливается слюноотделение и мочеиспускание, беспокойство. Поэтому уколы никогда не делают без предварительной диагностики. Дозировку для собаки подбирает лечащий ветеринар по массе тела.
Имидокарб блокирует поступление в эритроциты витаминоподобного вещества инозитола. Без него пироплазмы не могут существовать и погибают. Лекарства группы имидокарба выпускаются в форме готового раствора для инъекций.
Уколы делают подкожно 1 раз. Если возбудитель остаётся в крови через сутки, то инъекцию повторяют. Лекарства нельзя вводить внутривенно.
Препараты с имидокарбом менее токсичны, но по действию на паразитов не уступают. Побочные последствия развиваются реже. Иногда усиливается выделение слюны, беспокойство, возникает рвота.
Для облегчения состояния собаке колют преднизолон: 2 мг на 1 кг массы тела дважды в день в течение двух суток. Он подавляет иммунную реакцию, снимают признаки аллергии, интоксикации, стимулирует рост эритроцитов. Вместо человеческого лекарства можно проколоть ветеринарный раствор с преднизолоном Преднивет.
Если захватить болезнь на ранней стадии, собака благополучно выздоравливает без вспомогательных лекарств. В тяжёлых случаях подключают капельницу. Вводят растворы хлорида натрия, рингера, глюкозы 5%. Они восстанавливают водно-солевой баланс, усиливает выработку мочи, вместе с ней выходят токсичные вещества.
Дополнительные препараты назначают по результатам биохимических анализов крови и мочи. Они показывают, какие органы нуждаются в поддержке. Собаке могут понадобиться:
Гепатопротекторы восстанавливают функции печени, хотя половина ветеринаров считают их бесполезными. Препараты назначают курсом. После лечения лучше пользоваться лекарствами на растительной основе.
Витамины группы B, C участвуют в восстановлении нормального уровня красных кровяных клеток. Иммуномодуляторы улучшают обменные процессы, укрепляют защитные свойства органов. Препараты для восстановления функций сердца и лёгких назначают при нарушении дыхания, кровообращения, сбоях сердечной мышцы.
Вот примеры конкретных лекарств:
Растительные гепатопротекторы:
|
Иммуномодуляторы и витамины:
|
Для поддержки сердца и лёгких:
Оживлённость собаки после купирования острой стадии обманчива и не означает полного выздоровления. Болезнь затрагивает все органы, поэтому на 2 – 4 недели животное переводят на щадящий режим. Не дают физических нагрузок, оберегают от переохлаждений, перегрева. Прогулки сокращают по времени, но выводят на улицу каждые 4 часа, чтобы пёс вовремя освобождал мочевой пузырь. Рацион собаки после пироплазмоза зависит от того, какие органы пострадали во время болезни. Диету разрабатывает ветеринар по результатам биохимии крови и мочи. Вот общие принципы питания после болезни:
Профилактика пироплазмоза у собакиПосле каждой прогулки собаку осматривают. Шерсть расчёсывают, чтобы убрать клещей с поверхности. Присосавшихся вредителей сразу удаляют. Сначала смачивают ватку нашатырным спиртом, оборачивают паразита. Затем держат несколько секунд и вытаскивают выкручивающим движением. Размер голодных иксодовых клещей не превышает 2 – 4 мм. На тёмной или густой шерсти их трудно увидеть. Поэтому осмотры после прогулок не всегда спасают от заражения. Единственный способ уберечь собаку – пользоваться защитными средствами от клещей. Препараты различаются сроком и степенью защиты от вредителей, уровнем токсичности:
Все препараты, кроме растительных, содержат ядовитые компоненты и дают побочные эффекты. Чем токсичнее средство, тем лучше защищает от последствий укусов клещей. В таблице перечисляются названия действенных препаратов по группам:
Для защиты от клещей продаются комбинезоны. Акарицидным средством обрабатывают не животное, а складки одежды на горловине, по длине туловища, внизу конечностей. Паразиты ползут по ткани, попадают в карманы-ловушки и погибают. Пироплазмоз – тяжёлая, но излечимая болезнь. Её исход зависит от чуткости и расторопности хозяина. При малейших тревожных симптомах питомца лучше отвести в клинику, где врач диагностирует пироплазмоз у собаки, назначит лечение, препараты. Восстановление после острой стадии протекает по-разному. У одних болезнь проходит бесследно, у других напоминает о себе спустя месяцы и годы.
Дорогие читатели, если статья понравилась, делитесь ссылкой с друзьями в социальных сетях. |
Читайте также:





 Реабилитация после излечения
Реабилитация после излечения










